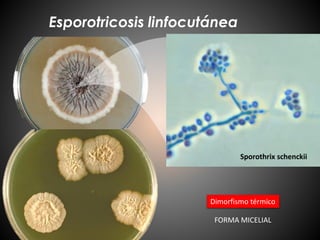
Esporotricosis linfocutánea
Sporothrix schenckii
Dimorfismo térmico
FORMA MICELIAL

El documento describe diferentes tipos de micosis subcutáneas, incluyendo la esporotricosis linfocutánea causada por el hongo Sporothrix schenckii, la cromoblastomicosis causada por varios hongos como Fonsecaea pedrosoi, y el micetoma eumicótico. La esporotricosis linfocutánea se presenta comúnmente como lesiones nodulares, verrugosas o ulceradas en la piel y puede diseminarse. S. schenckii exhibe dimorfismo térmico y la infección se trata con